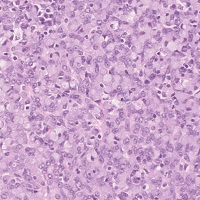

【子宮体部/非腫瘍性】

子宮腺筋症
.jpg)
子宮内膜増殖症(単純型)
.jpg)
子宮内膜増殖症(複雑型)

子宮内膜異型増殖症

子宮内膜ポリープ

アリアス・ステラ反応
【子宮体部/良性腫瘍】

富細胞平滑筋腫

脂肪平滑筋腫

良性上皮性・間葉性混合腫瘍
【子宮体部/悪性腫瘍】

類内膜腺癌

粘液性腺癌

漿液性腺癌

明細胞腺癌

扁平上皮癌

小細胞癌

低悪性度子宮内膜間質肉腫

悪性上皮性・間葉性混合腫瘍

悪性上皮性・間葉性混合腫瘍
【卵管/非腫瘍性】

卵管炎

卵管妊娠
【卵巣/非腫瘍性】

卵胞性嚢胞

Stein-Leventhal症候群

子宮内膜症性囊胞
【卵巣/良性腫瘍】

漿液性嚢胞腺腫

漿液性腺線維腫

粘液性嚢胞腺腫

ブレンナー腫瘍

線維腫

莢膜細胞腫

成熟奇形腫
【卵巣/境界悪性】

漿液性境界悪性腫瘍

粘液性境界悪性腫瘍

境界悪性ブレンナー腫瘍
【卵巣/悪性腫瘍】
Krukenberg腫瘍

漿液性腺癌

粘液性腺癌

類内膜腺癌

明細胞腺癌

悪性ブレンナー腫瘍

顆粒膜細胞腫

セルトリ・ライデッヒ細胞腫

ディスジャーミノーマ

卵黄嚢腫瘍

未熟奇形腫